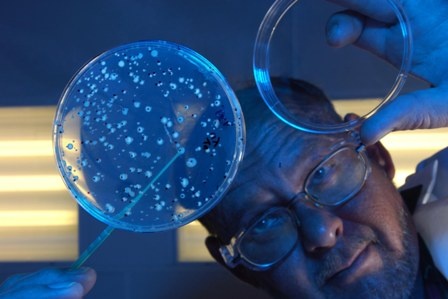
DuPont scientist Paul Viitanen develops biocatalysts for the DuPont Danisco...

DuPont Buys Danish Danisco for $5.8 Billion

U.S. Chemicals firm DuPont said on Sunday it will buy Danish food ingredients and enzymes firm Danisco for $5.8 billion, in a rare large deal that should boost its position in the fast-growing food sector.
The cash deal would enable DuPont to enter a niche in the chemical industry - food additives - long dominated by smaller rival International Flavors and Fragrances Inc. However the acquisition will reduce DuPont's 2011 earnings of $3.30 to $3.60 per share by a range of 30 cents to 45 cents per share, the company said.
The deal is structured as a public tender offer valuing Danisco's shares at DKK 665 in cash per share. Danisco is to recommend the offer to its shareholders, DuPont said.
Danisco's shares closed on Friday at 530 DKK, meaning the deal is at a 25% premium to its closing share price. DuPont's shares closed on Friday down 22 cents at $49.76.The company has a market capitalization of about $45 billion.
Shift In Focus
Traditionally, DuPont has focused on chemicals and safety and protection equipment. The firm is most well known for its iconic Kevlar bulletproof vests and Tyvek homewrap, not biologically engineered corn or soybean.
But DuPont's last high-profile acquisition, its 1999 purchase of seed maker Pioneer for $7.7 billion, began strategy shift toward a so-called "mega trend" of food and nutrition.
Many analysts at the time saw the price former CEO Charles Holliday paid as too much, though few dispute now that the Pioneer buyout helped save DuPont during the recession of 2008. Holliday is no longer with the company, and now serves as chairman of Bank of America.
The Danisco acquisition would be the first major deal for chief Executive Ellen Kullman since she took control of DuPont about two years ago.
It would also offer her a chance to leave a lasting legacy on the company, the way Holliday's buyout of Pioneer continues to define his tenure.
DuPont said it is already a joint venture partner with Danisco in the development of cellulosic ethanol technology.
DuPont, which will assume $500 million of Danisco's net debt said the deal is expected to be financed with about $3 billion in existing cash and the remainder in debt.
It expects the deal to close early in the second quarter and be cash and earnings accretive in 2012.
Danisco in December posted a bigger rise than expected in second-quarter profits, driven by efficiency measures and sales growth, and nudged up full-year guidance.
Company
DuPont Company101.Beech St. 16-1216
19880 Wilmington
most read

Ratcliffe: Chemical Industry in Europe at a Tipping Point
Ineos CEO Ineos calls on European politicians to save the chemical industry.

Merck Acquires Chromatography Business from JSR Life Sciences
Merck to acquire the chromatography business of JSR Life Sciences, a leading provider of CDMO services, preclinical and translational clinical research, and bioprocessing solutions.

Novo Nordisk to Cut 9,000 Jobs Globally in Major Restructuring
Novo Nordisk announced a global workforce reduction of approximately 9,000 positions to streamline operations and reinvest DKK 8 billion (€1 billion) in growth opportunities for diabetes and obesity treatments.

BASF Sells Majority Stake in Coatings Business
BASF sells a majority stake in its coatings business to the investor Carlyle.

CHEManager International Media Kit 2026
Compelling solutions through strategic partnerships





